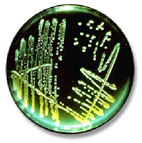

Organ
of the
GD — Society for Dermopharmacy
 |
|
Issue October 2000 |
Dermatika-News
Fluconazol
Long-term Therapy for Onychomycoses
Mycoses pedis and fingernail mycoses hold one of the topmost ranks within the infectious diseases regarding their incidence. Their treatment still today calls for a lot of patience and a thorough therapy. A rapid solution of the problem can hardly be found and the skeletal traction is nowadays considered to be completely unsuitable. Professor Dr. med. Claus Seebacher, medical superintendent of the Hautklinik (Dermatological clinic) of the hospital Dresden-Friedrichstadt, spoke for a simultaneous topical and systemical treatment enhanced by the factor time in a conversation with DermoTopics. This combination achieves the best, lasting and most cost-effective results as can be proved.
As Seebacher explained, even when applying the new antimycotics the minimal inhibitory concentration of which lies within the nanogram-sphere, an eradication of the fungi can only be obtained in few cases after a short-term therapy.
The
current antimycotics, both the Azoles (Fluconazol, Itraconazol) and the
Terbinafin are effective at different stages of the biosynthesis of Ergosterol.
If however, a fungus rests and does not reproduce it does not require Ergosterol
and consequently these antimycotics have no effect on the resting germ.
"We could prove this phenomenon by setting the cells of the same fungus
strain in rest, i.e. we have put it in physiologic saline solution. We have
set the same number into growth-stimulating Sabouraud solution", Seebacher
explained. The result was that the resting germs required a thousandfold
quantity of Terbinafin to be destroyed. This dosage however, cannot be administered
to someone. An additional aspect is that the germs - mycelia which decompose
into arthro spores lie in the nail keratin. Faveolate, air-containing canaliculi
develop in the subungual tissue which can have a thickness of up to ten
millimeters. Fungus spores can lie in these cavities which are however inaccessible
for any medicament.
The
current antimycotics, both the Azoles (Fluconazol, Itraconazol) and the
Terbinafin are effective at different stages of the biosynthesis of Ergosterol.
If however, a fungus rests and does not reproduce it does not require Ergosterol
and consequently these antimycotics have no effect on the resting germ.
"We could prove this phenomenon by setting the cells of the same fungus
strain in rest, i.e. we have put it in physiologic saline solution. We have
set the same number into growth-stimulating Sabouraud solution", Seebacher
explained. The result was that the resting germs required a thousandfold
quantity of Terbinafin to be destroyed. This dosage however, cannot be administered
to someone. An additional aspect is that the germs - mycelia which decompose
into arthro spores lie in the nail keratin. Faveolate, air-containing canaliculi
develop in the subungual tissue which can have a thickness of up to ten
millimeters. Fungus spores can lie in these cavities which are however inaccessible
for any medicament.This is the explanation as to why the problem onychomycosis cannot be solved by a modern short-term drug therapy.
Therapy Perseverance Pays Worthwhile
Due to the fact that nails grow very slowly, it could be that even after one year's time and with highly motivated and "co-operating" patients a complete healing cannot be achieved. If necessary a systemical continued treatment with Fluconazol or Itraconazol has to be taken in consideration.
150 milligrams of Fluconazol (Diflucan® Derm) once a week are sufficient for this therapy whereas unwanted effects are hardly to be expected. Fluconazol proves already effective in this comparably low dosage due to the fact that it accumulates selectively in the keratin both in the stratum corneum but also in the nail keratin in an approximately fortyfold higher concentration than in the plasma. The studies already published in this context are promising according to Seebacher. The best results have been obtained on average after a nine-months' long-term therapy. The advantage lies in the circumstance that also resting fungus cells are shed within the normal regeneration process of the nail growth. Thus the healing prospects increase. Therefore, if the time factor contributes, the therapeutical results of the treatment are more favourable than applying a short-term therapy.
| Diflucan ®Derm has not yet been authorised for the treatment of the onychomycosis in Germany, however, it can be applied for a therapy test. |
top